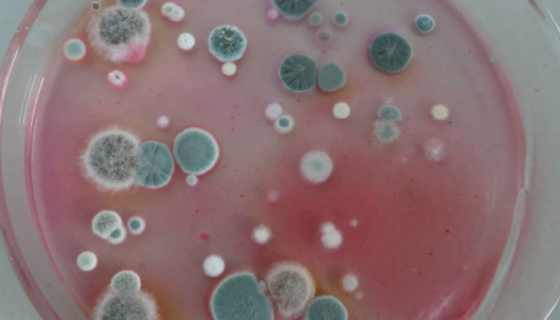
霉菌酵母菌检测过程中常见问题及解答！

表皮葡萄球菌的致病与诊断及实验室检查!
表皮葡萄球菌是广泛存在于皮肤表面的条件致病菌,随着抗生素的广...

人乳腺成纤维细胞的运输和保存及使用方法!
人乳腺成纤维细胞分离自乳腺组织;乳腺位于皮下浅筋膜的浅层与深...

实验室分离人表皮黑色素细胞的方法及操作步骤!
人表皮黑色素细胞分离自皮肤组织;表皮位于动物皮肤的外层,由胚...

变色栓菌的形态特征与生长环境及育植技术!
变色栓菌(学名:Trametes versicolor (L...

近平滑假丝酵母的培养条件与注意事项及保藏方法!
近平滑假丝酵母是Candida属的微生物,原产地为中国。表面...

群结腐霉的知识简介与形态描述及相关论述!
群结腐霉,菌落在CMA上无特定形态。菌丝发达,分枝,粗3.6...

小鼠肺癌细胞带绿色荧光的培养方法及到货须知!
小鼠肺癌细胞带绿色荧光仅用于科学研究或者工业应用等非医疗目的...
霉菌酵母菌检测过程中常见问题及解答!
汇聚行业网友见解,传递微生物检测知识,本次列出的问题均是ù菌...
